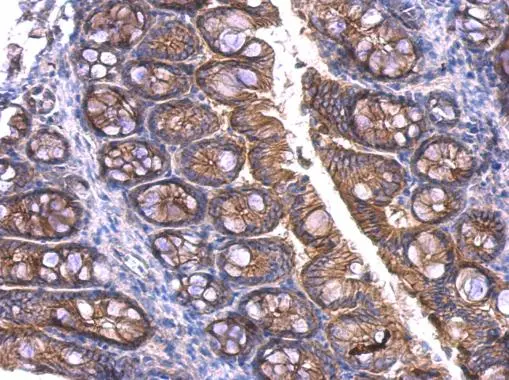
beta Catenin antibody detects beta Catenin protein at membrane on mouse colon by immunohistochemical analysis. Sample: Paraffin-embedded mouse colon. beta Catenin antibody (GTX101254) dilution: 1:500. 
 Antigen Retrieval: Trilogy? (EDTA based, pH 8.0) buffer, 15min

beta Catenin antibody detects beta Catenin protein at membrane on mouse intestine by immunohistochemical analysis. Sample: Paraffin-embedded mouse intestine. beta Catenin antibody (GTX101254) dilution: 1:500.
Antigen Retrieval: Trilogy? (EDTA based, pH 8.0) buffer, 15min
beta Catenin antibody
GTX101254
ApplicationsImmunoFluorescence, Western Blot, ImmunoCytoChemistry, ImmunoHistoChemistry, ImmunoHistoChemistry Paraffin
Product group Antibodies
ReactivityHuman, Mouse
TargetCTNNB1
Overview
- SupplierGeneTex
- Product Namebeta Catenin antibody
- Delivery Days Customer9
- Application Supplier NoteWB: 1:500-1:3000. IHC-P: 1:100-1:1000. *Optimal dilutions/concentrations should be determined by the researcher.Not tested in other applications.
- ApplicationsImmunoFluorescence, Western Blot, ImmunoCytoChemistry, ImmunoHistoChemistry, ImmunoHistoChemistry Paraffin
- CertificationResearch Use Only
- ClonalityPolyclonal
- Concentration1.01 mg/ml
- ConjugateUnconjugated
- Gene ID1499
- Target nameCTNNB1
- Target descriptioncatenin beta 1
- Target synonymsCTNNB, EVR7, MRD19, NEDSDV, armadillo, catenin beta-1, catenin (cadherin-associated protein), beta 1, 88kDa
- HostRabbit
- IsotypeIgG
- Protein IDP35222
- Protein NameCatenin beta-1
- Scientific DescriptionBeta-catenin is an adherens junction protein. Adherens junctions (AJs; also called the zonula adherens) are critical for the establishment and maintenance of epithelial layers, such as those lining organ surfaces. AJs mediate adhesion between cells, communicate a signal that neighboring cells are present, and anchor the actin cytoskeleton. In serving these roles, AJs regulate normal cell growth and behavior. At several stages of embryogenesis, wound healing, and tumor cell metastasis, cells form and leave epithelia. This process, which involves the disruption and reestablishment of epithelial cell-cell contacts, may be regulated by the disassembly and assembly of AJs. AJs may also function in the transmission of the contact inhibition signal, which instructs cells to stop dividing once an epithelial sheet is complete.[supplied by OMIM]
- ReactivityHuman, Mouse
- Storage Instruction-20°C or -80°C,2°C to 8°C
- UNSPSC12352203
References
- Zuo Z, Ji S, He L, et al. LncRNA TTN-AS1/miR-134-5p/PAK3 axis regulates the radiosensitivity of human large intestine cancer cells through the P21 pathway and AKT/GSK-3β/β-catenin pathway. Cell Biol Int. 2020,44(11):2284-2292. doi: 10.1002/cbin.11436Read this paper
- Liu J, Cao L, Zhao N, et al. miR‑338‑3p inhibits A549 lung cancer cell proliferation and invasion by targeting AKT and β‑catenin signaling pathways. Mol Med Rep. 2019,20(1):33-40. doi: 10.3892/mmr.2019.10215Read this paper
- Wu ZH, Tao ZH, Zhang J, et al. MiRNA-21 induces epithelial to mesenchymal transition and gemcitabine resistance via the PTEN/AKT pathway in breast cancer. Tumour Biol. 2016,37(6):7245-54. doi: 10.1007/s13277-015-4604-7Read this paper
- Mohapatra S, Chakraborty T, Shimizu S, et al. Starvation beneficially influences the liver physiology and nutrient metabolism in Edwardsiella tarda infected red sea bream (Pagrus major). Comp Biochem Physiol A Mol Integr Physiol. 2015,189:1-10. doi: 10.1016/j.cbpa.2015.07.003Read this paper
- Król M, Mucha J, Majchrzak K, et al. Macrophages mediate a switch between canonical and non-canonical Wnt pathways in canine mammary tumors. PLoS One. 2014,9(1):e83995. doi: 10.1371/journal.pone.0083995Read this paper
- Hong GM, Bain LJ. Arsenic exposure inhibits myogenesis and neurogenesis in P19 stem cells through repression of the β-catenin signaling pathway. Toxicol Sci. 2012,129(1):146-56. doi: 10.1093/toxsci/kfs186Read this paper

![WB analysis of HeLa whole cell lysate using GTX00948 beta Catenin antibody [GT1186]. Dilution : 1:1000](https://www.genetex.com/upload/website/prouct_img/normal/GTX00948/GTX00948_20200327_WB_1_w_23053121_214.webp)
![Immunohistochemical analysis of paraffin-embedded zebrafish tissue, using beta Catenin antibody [N1N2-2], N-term (GTX101435) at 1:300 dilution.](https://www.genetex.com/upload/website/prouct_img/normal/GTX101435/GTX101435_39876_IHC_22111422_262.webp)



